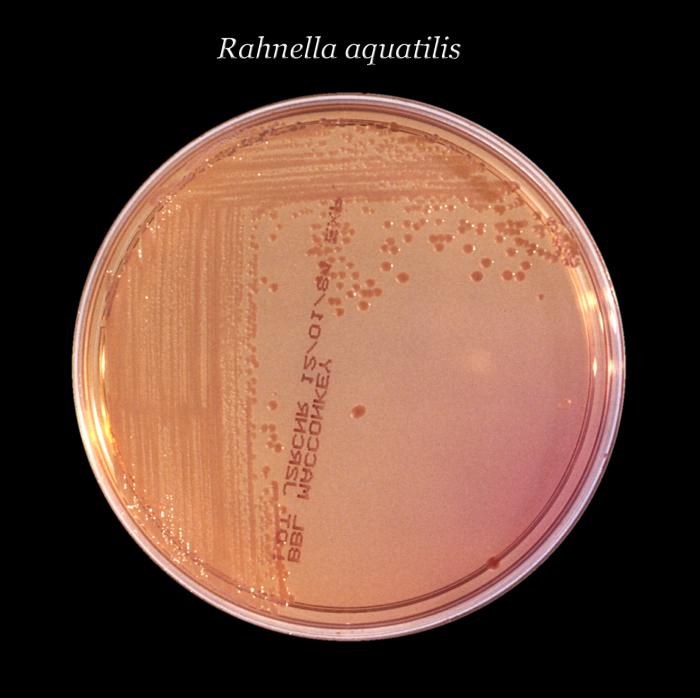
form teachers 6 for Library(PHIL) Image Public  Health  Details

4 INFO FORM 6 FOR TEACHERS PDF ZIP DOCX PRINTABLE DOWNLOAD
INFO FORM 6 FOR TEACHERS PDF ZIP DOCX PRINTABLE DOWNLOAD
Hello, thank you for visiting this url to look for form 6 for teachers. I really hope the article that appears could be beneficial to you









The Elements 2019 12 x 12 Inch Monthly Square Wall , Bilborough College Tes Jobs , Sharecropping by Aaron G , Humanitarian aid Spc. Ryan Satterfield of 3rd Plt , Humanitarian aid Flickr Photo Sharing! , Nematocysts by Chandler Hageman , Details Public Health Image Library(PHIL) , Edvard Grieg – Composer « Charlotte Hoather , Which Are the First 3 Puerto Rican Spanish Words Kids , The Dark at the Top of the Stairs The Lee Strasberg , Thanksgiving: Indulging in Gratitude 1 Thessalonians 5 , Preamble by Tracey J , California Impressionism Wikipedia , Girls swimming teams compete well at National swimming , form 6 for teachers,
Hello, thank you for visiting this url to look for form 6 for teachers. I really hope the article that appears could be beneficial to you

Belum ada Komentar untuk "4 INFO FORM 6 FOR TEACHERS PDF ZIP DOCX PRINTABLE DOWNLOAD"
Posting Komentar